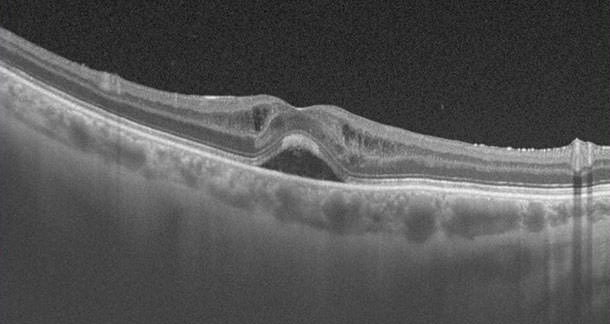
OCT - Retina - VERTE Oftalmología Barcelona

El estudio es totalmente indoloro sin efectos adversos asociados. De forma excepcional, durante el examen pueden percibirse discretas molestias oculares como picor o lagrimeo que remiten al finalizar el examen. Ello pasa por tener que parpadear menos durante los instantes que se hace la prueba. No existe ninguna contraindicación para la práctica de la tomografía.

